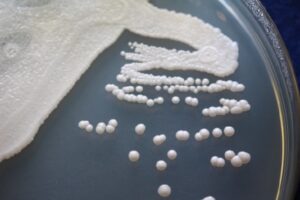

Bolsonaro espera definir nome para o Meio Ambiente nesta semana
O presidente eleito, Jair Bolsonaro, disse hoje (2) que espera decidir o nome que ocupará o Ministério do Meio Ambiente nesta semana. Bolsonaro falou

O presidente eleito, Jair Bolsonaro, disse hoje (2) que espera decidir o nome que ocupará o Ministério do Meio Ambiente nesta semana. Bolsonaro falou

Uma série de ferramentas nas mãos, dezenas de pneus e muita disposição. Essa é a formula diária que a moradora

As infecções hospitalares causadas por fungos multirresistentes devem se tornar cada vez mais comuns, segundo o pesquisador do Instituto de

Em ritmo de fim de ano e ações a todo vapor, o grupo Flor Ribeirinha abre o quintal para as

O presidente Michel Temer fez neste sábado (1º) um balanço das realizações do governo federal na região Nordeste do país.

Composições que exaltam as raízes africanas na música e denunciam o racismo – e na mesma dose se debruçam no

O Supermercado Comper do Jardim Petrópolis, localizado na Fernando Correa, esquina com a Avenida Carmindo e Campos, foi alvo de

Na madrugada deste domingo (02), três jovens, sendo dois menores de idade, foram apreendidos, durante uma corrida com aplicativo de

“Prometi à minha família que não voltaria para casa sem fazer barulho no mundo. Eles sempre me apoiaram e o

A Polícia Militar do 5º CR apreendeu nesse sábado (1º), na cidade de General Carneiro (MT), 1.433 tabletes de maconha

O presidente eleito, Jair Bolsonaro, disse hoje (2) que espera decidir o nome que ocupará o Ministério do Meio Ambiente nesta semana. Bolsonaro falou com jornalistas na entrada do avião em que embarcou para

Uma série de ferramentas nas mãos, dezenas de pneus e muita disposição. Essa é a formula diária que a moradora do bairro Pedra 90 — na periferia de Cuiabá, Miriam Oliveira, de
As infecções hospitalares causadas por fungos multirresistentes devem se tornar cada vez mais comuns, segundo o pesquisador do Instituto de Medicina Tropical da Universidade de São Paulo João Nóbrega de

Em ritmo de fim de ano e ações a todo vapor, o grupo Flor Ribeirinha abre o quintal para as primeiras vivências de um novo ciclo do “Semente Ribeirinha”, projeto

O presidente Michel Temer fez neste sábado (1º) um balanço das realizações do governo federal na região Nordeste do país. Ao conceder entrevista para o cientista político Antônio Lavareda, Temer

Composições que exaltam as raízes africanas na música e denunciam o racismo – e na mesma dose se debruçam no amor e erotismo – compõem o segundo álbum de Baco

O Supermercado Comper do Jardim Petrópolis, localizado na Fernando Correa, esquina com a Avenida Carmindo e Campos, foi alvo de um assalto na madrugada deste domingo (02), em Cuiabá. Funcionários

Na madrugada deste domingo (02), três jovens, sendo dois menores de idade, foram apreendidos, durante uma corrida com aplicativo de transporte, suspeitos de realizarem um assalto no bairro CPA 1,

“Prometi à minha família que não voltaria para casa sem fazer barulho no mundo. Eles sempre me apoiaram e o que tenho a dizer é que é só o começo

A Polícia Militar do 5º CR apreendeu nesse sábado (1º), na cidade de General Carneiro (MT), 1.433 tabletes de maconha em um caminhão que transportava ração bovina da cidade de